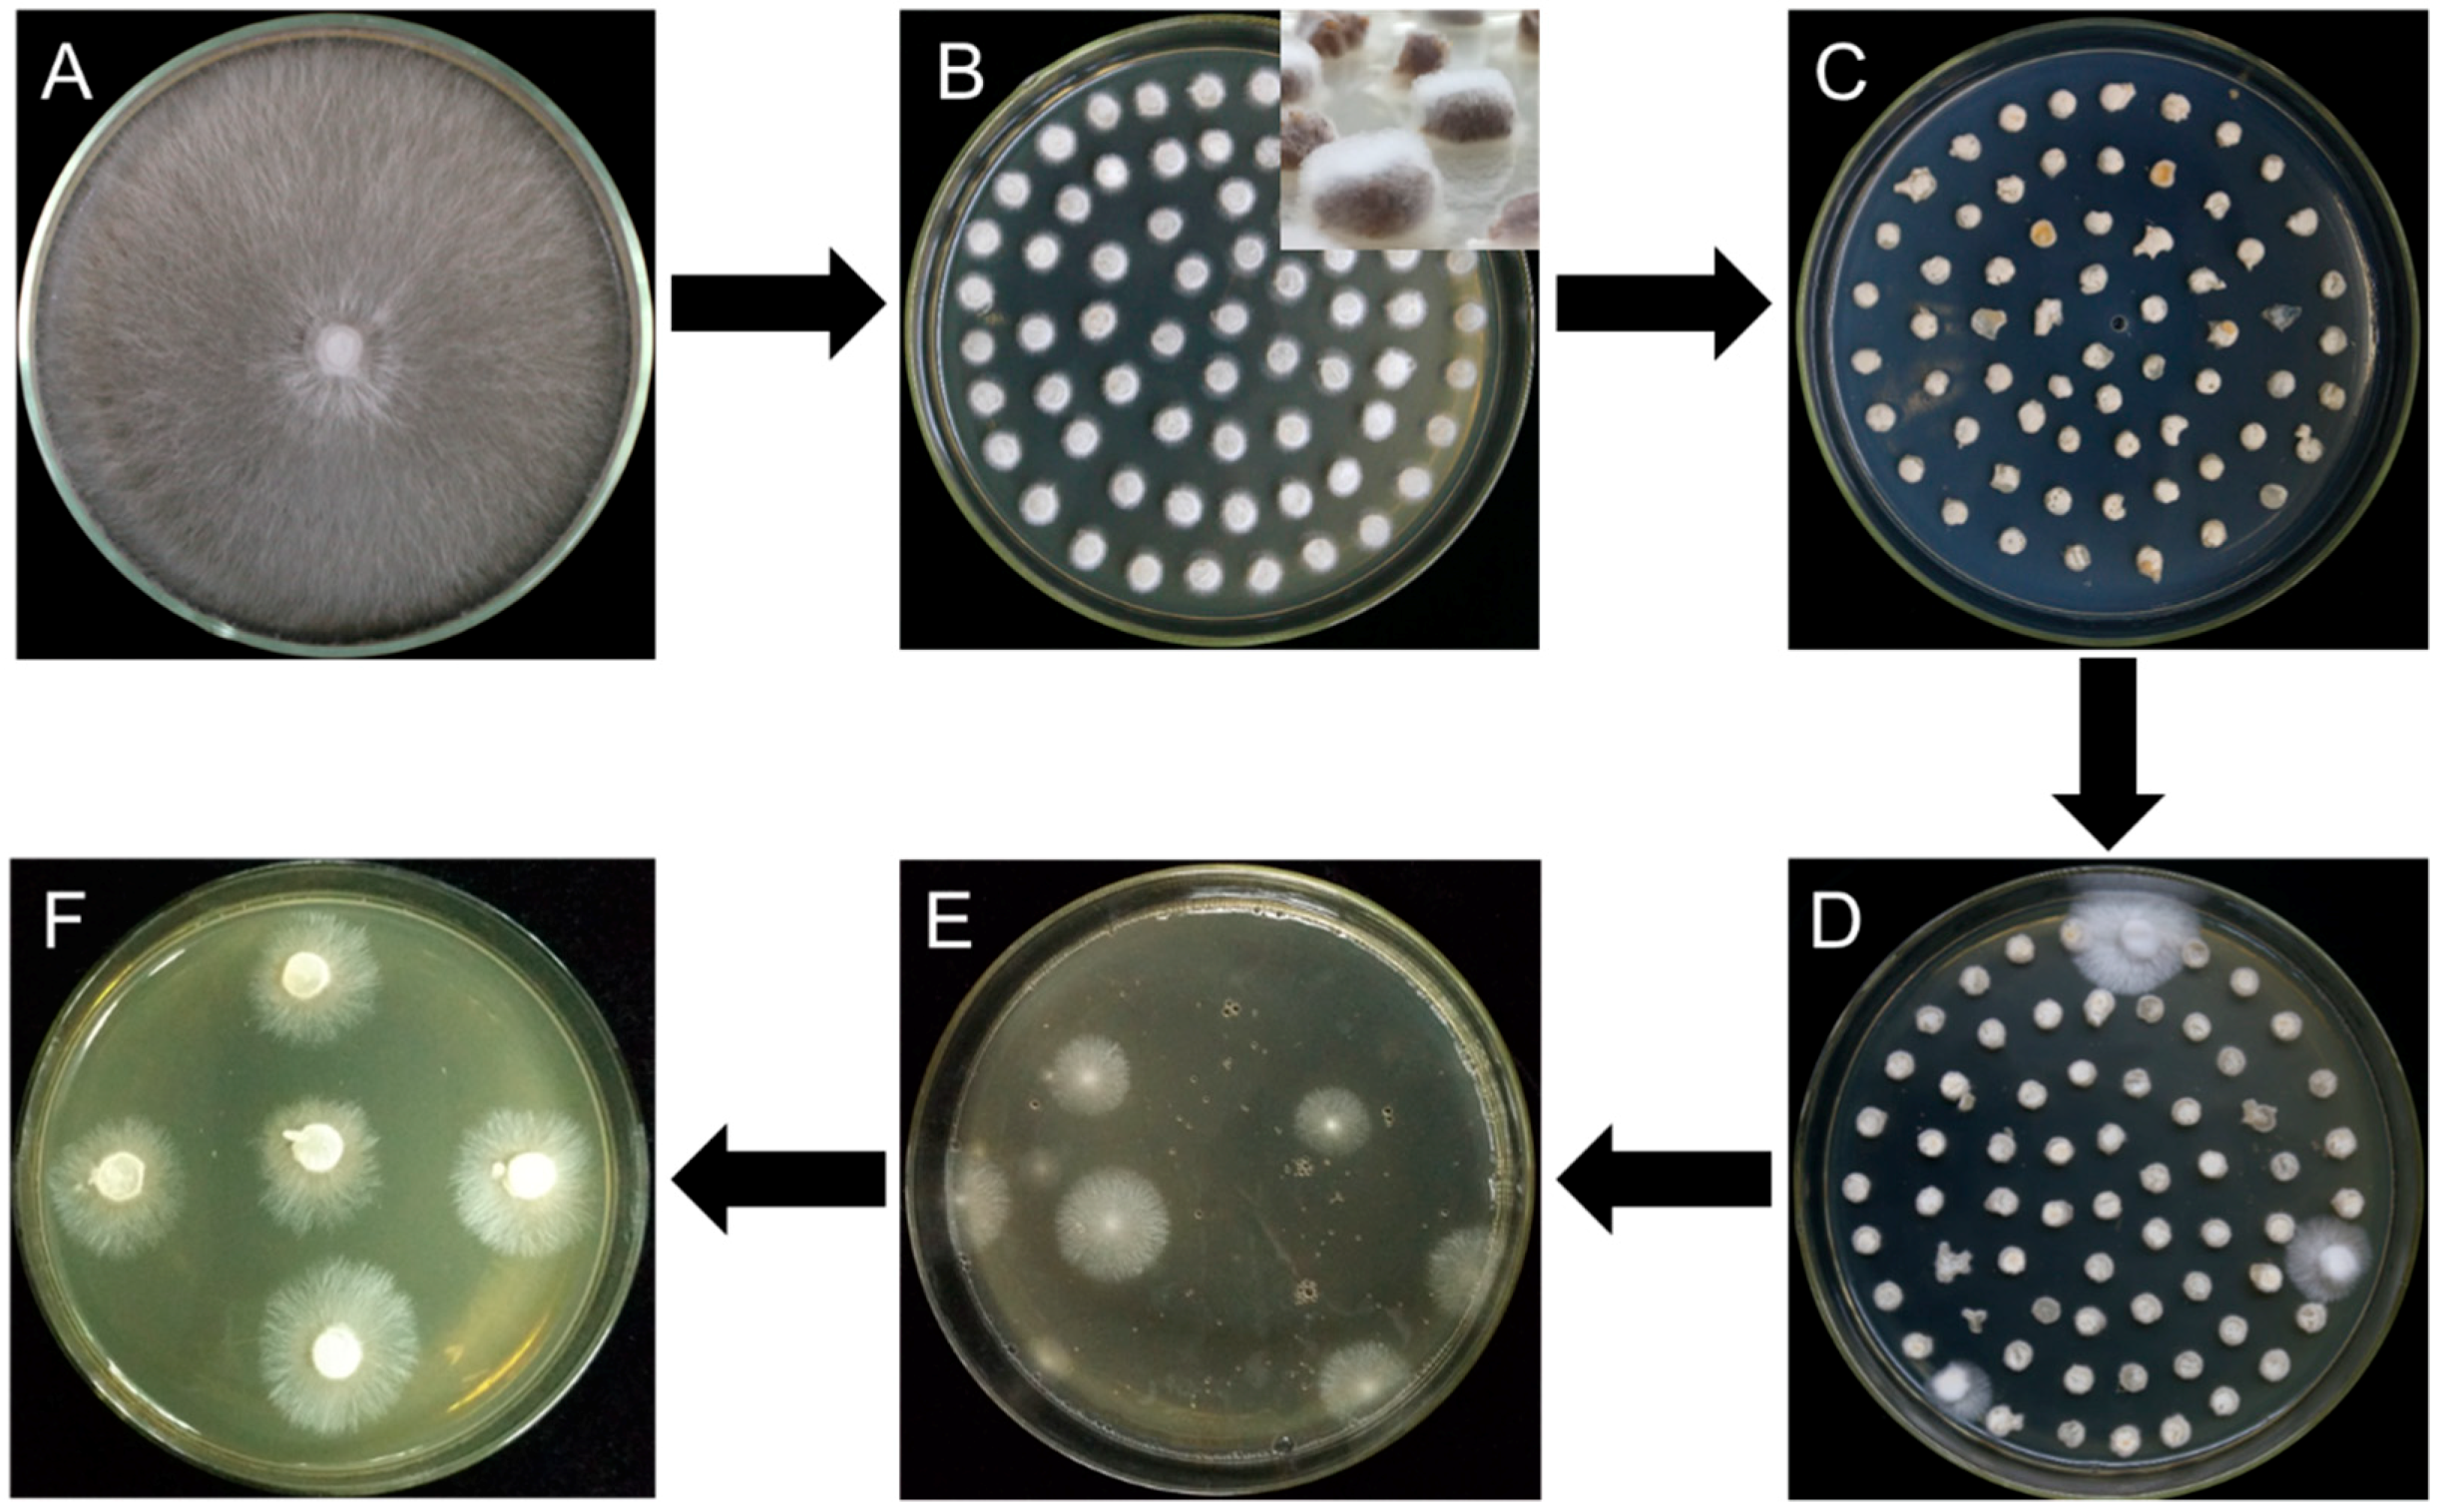
Genes 10 00467 g002

Effects of Medium Composition and Genetic Background on Agrobacterium-Mediated Transformation Efficiency of Lentinula edodes
Abstract
1. Introduction
2. Materials and Methods
2.1. Strains and Culture Conditions
2.2. Plasmid Construction
2.3. A. Tumefaciens-Mediated Transformation
2.4. Molecular Analysis of Transformants
3. Results
3.1. Effect of A. tumefaciens Strains and AS Concentration on Transformation Efficiency
3.2. Effect of Activation Medium on the Transformation Efficiency of Dikaryotic and Monokaryotic Strains
3.3. ATMT Transformation Efficiency in Different L. edodes Strains
3.4. Molecular Analysis of Transformants
3.5. Screening for eGFP Expression
4. Discussion
5. Conclusions
Author Contributions
Funding
Acknowledgments
Conflicts of Interest
Availability of Data and Materials
References
- Miles, P.G.; Chang, S.T. Mushrooms: Cultivation, Nutritional Value, Medicinal Effect, and Environmental Impact. In Chapter 1 Overview I Introduction; CRC Press: Boca Raton, FL, USA, 2004; pp. 1–25. [Google Scholar]
- Srivilai, P.; Chaisaena, W.; Kües, U. Genetic analysis of Coprinosis cinerea mutants with defects in fruiting body development. In VI Genetics and Cellular Biology of Basidiomycetes; Antonio, G.P., Lucy, R., Eds.; Universida Pública de Navarra: Pamplona, Spain, 2005; pp. 177–189. [Google Scholar]
- Ohm, R.A.; De Jong, J.F.; Lugones, L.G.; Aerts, A.; Kothe, E.; Stajich, J.E.; De Vries, R.P.; Record, E.; Levasseur, A.; Baker, S.E.; et al. Genome sequence of the model mushroom Schizophyllum commune. Nat. Biotechnol. 2010, 28, 957. [Google Scholar] [CrossRef] [PubMed]
- Morin, E.; Kohler, A.; Baker, A.R.; Foulongne-Oriol, M.; Lombard, V.; Nagye, L.G.; Ohm, R.A.; Patyshakuliyeva, A.; Brun, A.; Aerts, A.L.; et al. Genome sequence of the button mushroom Agaricus bisporus reveals mechanisms governing adaptation to a humic-rich ecological niche. Proc. Natl. Acad. Sci. USA 2012, 109, 17501–17506. [Google Scholar] [CrossRef] [PubMed]
- Chen, S.; Xu, J.; Liu, C.; Zhu, Y.; Nelson, D.R.; Zhou, S.; Li, C.; Wang, L.; Guo, X.; Sun, Y.; et al. Genome sequence of the model medicinal mushroom Ganoderma lucidum. Nat. Commun. 2012, 3, 913. [Google Scholar] [CrossRef] [PubMed]
- Chen, L.; Gong, Y.; Cai, Y.; Liu, W.; Zhou, Y.; Xiao, Y.; Xu, Z.; Liu, Y.; Lei, X.; Wang, G.; et al. Genome sequence of the edible cultivated mushroom Lentinula edodes (shiitake) reveals insights into lignocellulose degradation. PLoS ONE 2016, 11, e0160336. [Google Scholar] [CrossRef] [PubMed]
- Cai, Y.; Gong, Y.; Liu, W.; Hu, Y.; Chen, L.; Yan, L.; Zhou, Y.; Bian, Y. Comparative secretomic analysis of lignocellulose degradation by Lentinula edodes grown on microcrystalline cellulose, lignosulfonate and glucose. J. Proteom. 2017, 163, 92–101. [Google Scholar] [CrossRef] [PubMed]
- Tang, L.H.; Jian, H.H.; Song, C.Y.; Bao, D.P.; Shang, X.D.; Wu, D.Q.; Tan, Q.; Zhang, X.H. Transcriptome analysis of candidate genes and signaling pathways associated with light-induced brown film formation in Lentinula edodes. Appl. Microbiol. Biotechnol. 2013, 97, 4977–4989. [Google Scholar] [CrossRef] [PubMed]
- Song, H.Y.; Kim, D.H.; Kim, J.M. Comparative transcriptome analysis of dikaryotic mycelia and mature fruiting bodies in the edible mushroom Lentinula edodes. Sci. Rep. 2018, 8, 8983. [Google Scholar] [CrossRef]
- Wang, G.Z.; Ma, C.J.; Luo, Y.; Zhou, S.S.; Zhou, Y.; Ma, X.L.; Cai, Y.L.; Yu, J.J.; Bian, Y.B.; Gong, Y.H. Proteome and transcriptome reveal involvement of heat shock proteins and indoleacetic acid metabolism process in Lentinula edodes thermotolerance. Cell. Phys. Biochem. 2018, 50, 1617–1637. [Google Scholar] [CrossRef]
- Wang, G.; Zhou, S.S.; Luo, Y.; Ma, C.; Gong, Y.; Zhou, Y.; Gao, S.; Huang, Z.; Yan, L.; Hu, Y.; et al. The heat shock protein 40 LeDnaJ regulates stress resistance and indole-3-acetic acid biosynthesis in Lentinula edodes. Fungal Genet. Biol. 2018, 118, 37–44. [Google Scholar] [CrossRef]
- Chao, M.A.; Wang, J.; Zheng, G.; Sha, Z.; Luo, S.; Gong, Y.; Hua, Y.; Yin, B. RNAi Functional analyses of anthranilate synthase gene LetrpE in Lentinula edodes by RNAi mediated gene knockdown. Mycosystema 2018, 37, 576–583. [Google Scholar]
- Nakade, K.; Watanabe, H.; Sakamoto, Y.; Sato, T. Gene silencing of the Lentinula edodes lcc1 gene by expression of a homologous inverted repeat sequence. Microbiol. Res. 2011, 166, 484–493. [Google Scholar] [CrossRef] [PubMed]
- Sato, T.; Takahashi, M.; Hasegawa, J.; Watanabe, H. Overexpression and repression of the tyrosinase gene in Lentinula edodes using the pChG vector. J. Biosci. Bioeng. 2019. [Google Scholar] [CrossRef] [PubMed]
- Jiang, D.; Zhu, W.; Wang, Y.; Sun, C.; Zhang, K.Q.; Yang, J. Molecular tools for functional genomics in filamentous fungi: Recent advances and new strategies. Biotechnol. Adv. 2013, 31, 1562–1574. [Google Scholar] [CrossRef] [PubMed]
- Sharma Ghimire, P.; Jin, C. Genetics, Molecular, and Proteomics Advances in Filamentous Fungi. Curr. Microbiol. 2017, 74, 1226–1236. [Google Scholar] [CrossRef] [PubMed]
- Sato, T.; Yaegashi, K.; Ishii, S.; Hirano, T.; Kajiwara, S.; Shishido, K.; Enei, H. Transformation of the Edible Basidiomycete Lentinus edodes by Restriction Enzyme-Mediated Integration of Plasmid DNA. Biosci. Biotechnol. Biochem. 1998, 62, 2346–2350. [Google Scholar] [CrossRef] [PubMed]
- Hirano, T.; Sato, T.; Yaegashi, K.; Enei, H. Efficient transformation of the edible basidiomycete Lentinus edodes with a vector using a glyceraldehyde-3-phosphate dehydrogenase promoter to hygromycin B resistance. Mol. Gen. Genet. 2000, 263, 1047–1052. [Google Scholar] [CrossRef] [PubMed]
- Irie, T.; Sato, T.; Saito, K.; Honda, Y.; Watanabe, T.; Kuwahara, M.; Enei, H. Construction of a Homologous Selectable Marker Gene for Lentinula edodes Transformation. Biosci. Biotechnol. Biochem. 2003, 67, 2006–2009. [Google Scholar] [CrossRef] [PubMed]
- Li, G.; Li, R.; Liu, Q.; Wang, Q.; Chen, M.; Li, B. A highly efficient polyethylene glycol-mediated transformation method for mushrooms. FEMS Microbiol. Lett. 2006, 256, 203–208. [Google Scholar] [CrossRef]
- Kuo, C.Y.; Huang, C.T. A reliable transformation method and heterologous expression of β-glucuronidase in Lentinula edodes. J. Microbiol. Methods 2008, 72, 111–115. [Google Scholar] [CrossRef]
- Li, D.; Tang, Y.; Lin, J.; Cai, W. Methods for genetic transformation of filamentous fungi. Microb. Cell Fact. 2017, 16, 168. [Google Scholar] [CrossRef]
- Lv, S.; Chen, X.; Mou, C.; Dai, S.; Bian, Y.; Kang, H. Agrobacterium-mediated transformation of the ascomycete mushroom Morchella importuna using polyubiquitin and glyceraldehyde-3-phosphate dehydrogenase promoter-based binary vectors. World J. Microbiol. Biotechnol. 2018, 34, 1–10. [Google Scholar] [CrossRef] [PubMed]
- Liu, J.; Song, C.; Li, Q.; Xu, Z.; Zhang, D.; Zhang, M.; Tan, Q.; Shang, X. A colonized millet grain method for Agrobacterium-mediated transformation of the button mushroom Agaricus bisporus. J. Microbiol. Methods 2018, 152, 148–153. [Google Scholar] [CrossRef] [PubMed]
- Martínez-Cruz, J.; Romero, D.; de Vicente, A.; Pérez-García, A. Transformation of the cucurbit powdery mildew pathogen Podosphaera xanthii by Agrobacterium tumefaciens. New Phytol. 2017, 213, 1961–1973. [Google Scholar] [CrossRef] [PubMed]
- Sun, L.; Cai, H.; Xu, W.; Hu, Y.; Gao, Y.; Lin, Z. Efficient Transformation of the Medicinal Mushroom Ganoderma lucidum. Plant Mol. Biol. Rep. 2001, 19, 383a–383j. [Google Scholar] [CrossRef]
- Zhou, J.; Bai, Y.; Dai, R.; Guo, X.; Liu, Z.H.; Yuan, S. Improved Polysaccharide Production by Homologous Co-overexpression of Phosphoglucomutase and UDP Glucose Pyrophosphorylase Genes in the Mushroom Coprinopsis cinerea. J. Agric. Food Chem. 2018, 66, 4702–4709. [Google Scholar] [CrossRef] [PubMed]
- Michielse, C.B.; Hooykaas, P.J.J.; van den Hondel, C.A.M.J.J.; Ram, A.F.J. Agrobacterium-mediated transformation as a tool for functional genomics in fungi. Curr. Genet. 2005, 48, 1–17. [Google Scholar] [CrossRef] [PubMed]
- Ding, Y.; Liang, S.; Lei, J.; Chen, L.; Kothe, E.; Ma, A. Agrobacterium tumefaciens mediated fused egfp-hph gene expression under the control of gpd promoter in Pleurotus ostreatus. Microbiol. Res. 2011, 166, 314–322. [Google Scholar] [CrossRef]
- Kim, S.; Ha, B.S.; Ro, H.S. Current technologies and related issues for mushroom transformation. Mycobiology 2015, 43, 1–8. [Google Scholar] [CrossRef]
- Cheng, M.; Spencer, T.M.; Ye, X.; Armstrong, C.L.; Lowe, B.A. Factors influencing Agrobacterium-mediated transformation of monocotyledonous species. Vitr. Cell. Dev. Biol.-Plant 2004, 40, 31–45. [Google Scholar] [CrossRef]
- Xiao, Y.; Cheng, X.; Liu, J.; Li, C.; Nong, W.; Bian, Y.; Cheung, M.K.; Kwan, H.S. Population genomic analysis uncovers environmental stress-driven selection and adaptation of Lentinula edodes population in China. Sci. Rep. 2016, 6, 36789. [Google Scholar] [CrossRef]
- Liu, J.; Wang, Z.R.; Li, C.; Bian, Y.B.; Xiao, Y. Evaluating genetic diversity and constructing core collections of Chinese Lentinula edodes cultivars using ISSR and SRAP markers. J. Basic Microbiol. 2015, 55, 749–760. [Google Scholar] [CrossRef] [PubMed]
- Xiang, X.; Li, C.; Li, L.; Bian, Y.; Kwan, H.S.; Nong, W.; Cheung, M.K.; Xiao, Y. Genetic diversity and population structure of Chinese Lentinula edodes revealed by InDel and SSR markers. Mycol. Prog. 2016, 15, 37. [Google Scholar] [CrossRef]
- Li, C.; Gong, W.; Zhang, L.; Yang, Z.; Nong, W.; Bian, Y.; Kwan, H.S.; Cheung, M.K.; Xiao, Y. Association mapping reveals genetic loci associated with important agronomic traits in Lentinula edodes, shiitake mushroom. Front. Microbiol. 2017, 8, 237. [Google Scholar] [CrossRef] [PubMed][Green Version]
- Hooykaas, P.J.J.; Roobol, C.; Schilperoort, R.A. Regulation of the Transfer of TI Plasmids of Agrobacterium tumefaciens. J. Gen. Microbiol. 1979, 110, 99–109. [Google Scholar] [CrossRef]
- Bundock, P.; den Dulk-Ras, A.; Beijersbergen, A.; Hooykaas, P.J. Trans-kingdom T-DNA transfer from Agrobacterium tumefaciens to Saccharomyces cerevisiae. EMBO J. 1995, 14, 3206–3214. [Google Scholar] [CrossRef] [PubMed]
- Raimundo, J.; Reis, C.M.G.; Ribeiro, M.M. Rapid, simple and potentially universal method for DNA extraction from Opuntia spp. fresh cladode tissues suitable for PCR amplification. Mol. Biol. Rep. 2018, 45, 1405–1412. [Google Scholar] [CrossRef] [PubMed]
- Jiang, N.; Song, C.; Liu, J.; Tan, Q.; Zhang, L.; Shang, X. Agrobacterium-mediated transformation of the Lentinula edodes mycelia. Mycosystema 2017, 36, 1514–1523. [Google Scholar]
- Bae, T.W.; Park, H.R.; Kwak, Y.S.; Lee, H.Y.; Ryu, S.B. Agrobacterium tumefaciens-mediated transformation of a medicinal plant Taraxacum platycarpum. Plant Cell. Tissue Organ Cult. 2005, 80, 51–57. [Google Scholar] [CrossRef]
- Zhang, J.; Shi, L.; Chen, H.; Sun, Y.; Zhao, M.; Ren, A.; Chen, M.; Wang, H.; Feng, Z. An efficient Agrobacterium-mediated transformation method for the edible mushroom Hypsizygus marmoreus. Microbiol. Res. 2014, 169, 741–748. [Google Scholar] [CrossRef]
- Wang, J.; Guo, L.; Zhang, K.; Wu, Q.; Lin, J. Highly efficient Agrobacterium-mediated transformation of Volvariella volvacea. Bioresour. Technol. 2008, 99, 8524–8527. [Google Scholar] [CrossRef]
- Murata, H.; Sunagawa, M.; Yamazaki, T.; Shishido, K.; Igasaki, T. Expression of the autofluorescent protein, DsRed2, in the recombinants of the ectomycorrhizal basidiomycete, Suillus grevillei, generated by Agrobacterium-mediated transformation. Mycorrhiza 2006, 16, 407–412. [Google Scholar] [CrossRef] [PubMed]
- Simmonds, D.H.; Donaldson, P.A. Genotype screening for proliferative embryogenesis and biolistic transformation of short-season soybean genotypes. Plant Cell Rep. 2000, 19, 485–490. [Google Scholar] [CrossRef] [PubMed]
- Tie, W.; Zhou, F.; Wang, L.; Xie, W.; Chen, H.; Li, X.; Lin, Y. Reasons for lower transformation efficiency in indica rice using Agrobacterium tumefaciens-mediated transformation: Lessons from transformation assays and genome-wide expression profiling. Plant Mol. Biol. 2012, 78, 1–18. [Google Scholar] [CrossRef] [PubMed]

| Primer a | Sequence (5′ to 3′) |
|---|---|
| Pgpd-F | ccacctcaaacttcggaattcGCAGTCAATGGATTGGAGTGTATT |
| Pgpd-R | gctcaccatCGAAGTTTGAGGTGGTTGCG |
| gfp-F | ctcaaacttcgATGGTGAGCAAGGGCGAGG |
| gfp-R | tctagaggatccccgggtaccTTACTTGTACAGCTCGTCCATGCC |
| EGFP-F | ATGGTGAGCAAGGGCGAGGA |
| EGFP-R | TTACTTGTACAGCTCGTCCATG |
| hpt557-F | ACACTACATGGCGTGATTTCAT |
| hpt557-R | TCCACTATCGGCGAGTACTTCT |
| Medium | Strains | |||||
|---|---|---|---|---|---|---|
| W1 | W1-26 | |||||
| 1st (%) a | 2nd b | PF (%) c | 1st (%) a | 2nd b | PF (%) c | |
| MYG | 12.26 ± 2.04 | 7.00 ± 4.69 | 2.79 ± 3.23 | 16.51 ± 3.77 | 7.50 ± 2.08 | NA |
| M | 100.00 ± 0.00 | 8.00 ± 5.60 | 2.72 ± 3.17 | 50.00 ± 0.00 | 27.75 ± 3.59 | NA |
| 1/2 M | 95.00 ± 3.56 | 18.00 ± 4.32 | 9.59 ± 8.92 | 17.69 ± 4.63 | 28.00 ± 5.10 | NA |
| 1/4 M | 87.00 ± 2.43 | 21.00 ± 2.94 | 30.00 ± 7.07 | 15.79 ± 3.89 | 27.75 ± 5.32 | NA |
| Millet | 5.14 ± 2.05 | 1.75 ± 1.50 | 0.00 ± 0.00 | 96.22 ± 5.43 | 58.75 ± 10.78 | 75.48 ± 4.31 |
| Testing Item | Variety | ||||
|---|---|---|---|---|---|
| W1 | S606 | YS3357 | YS3334 | YS55 | |
| 1st (%) a | 12.26 ± 2.04 | 1.41 ± 0.40 | 1.97 ± 0.41 | 7.27 ± 2.94 | 32.96 ± 10.82 |
| 2nd b | 7.00 ± 4.69 | 49.50 ± 4.43 | 79.00 ± 8.83 | 85.25 ± 8.54 | 61.00 ± 16.02 |
| PF (%) c | 2.79 ± 3.23 | 18.86 ± 8.10 | 26.98 ± 14.55 | 85.12 ± 14.31 | 34.47 ± 16.62 |
© 2019 by the authors. Licensee MDPI, Basel, Switzerland. This article is an open access article distributed under the terms and conditions of the Creative Commons Attribution (CC BY) license (http://creativecommons.org/licenses/by/4.0/).
Share and Cite
Yan, L.; Xu, R.; Zhou, Y.; Gong, Y.; Dai, S.; Liu, H.; Bian, Y. Effects of Medium Composition and Genetic Background on Agrobacterium-Mediated Transformation Efficiency of Lentinula edodes. Genes 2019, 10, 467. https://doi.org/10.3390/genes10060467
Yan L, Xu R, Zhou Y, Gong Y, Dai S, Liu H, Bian Y. Effects of Medium Composition and Genetic Background on Agrobacterium-Mediated Transformation Efficiency of Lentinula edodes. Genes. 2019; 10(6):467. https://doi.org/10.3390/genes10060467
Chicago/Turabian StyleYan, Lianlian, Ruiping Xu, Yan Zhou, Yuhua Gong, Shenghong Dai, Haiyang Liu, and Yinbing Bian. 2019. "Effects of Medium Composition and Genetic Background on Agrobacterium-Mediated Transformation Efficiency of Lentinula edodes" Genes 10, no. 6: 467. https://doi.org/10.3390/genes10060467
APA StyleYan, L., Xu, R., Zhou, Y., Gong, Y., Dai, S., Liu, H., & Bian, Y. (2019). Effects of Medium Composition and Genetic Background on Agrobacterium-Mediated Transformation Efficiency of Lentinula edodes. Genes, 10(6), 467. https://doi.org/10.3390/genes10060467

